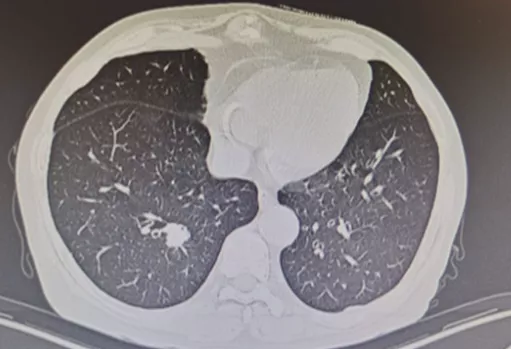

第一环节 肺结节临床诊治策略与进展
* 陈良安教授主讲
一、什么叫肺结节?
按照肺结节的密度,可分为实性结节、部分实性结节、亚实性或混合性结节、无实性或磨玻璃结节;根据肺结节的数目,可以分为孤立性肺结节(SPN)和多发性肺结节(MPN)。最近多发性肺结节的病人有所增加,临床上针对这类患者的诊断和处理方面还存在许多困难。

GGN影像病理基础

磨玻璃结节是一个比较特殊的结节情况,它有一定的影像病理基础,正常的肺泡照出来有很好的透光度,如果肺泡里面有一些成分,这个成分可能是细胞成分,也可能是液体成分,而且它们没有把肺泡充满,扫描出来的CT表现就是磨玻璃样结节,所以磨玻璃结节和其他的实性结节的影像病理基础是有区别的。并且,磨玻璃结节可以是炎性的,也可以是间质性改变,但是也可以是细胞增生的癌前病变,甚至是早期腺癌的表现。
肺结节的流行病学
根据国外肺结节流行病学情况,一项2015年美国某大型健康体检调查的报告,从中得出肺结节检出率从2006年的3.9/1000人年增至2012年的6.6/1000人年,上升较快;超过70岁以后,男性肺结节发病率高于女性。2017年法国SPN研究表明,2002-2003年,肺结节年龄标化发病率为10.2/100000人年,2004-2005年为12.6/100000人年,男性的发病率高于女性。我国近两年肺结节流行病学情况,像上海、福建、安徽、湖南也有一些体检报告,肺结节在健康人查体中的检出率在逐年增高。

我们课题组前期从2015年8月到2016年7月做了19637例的健康体检人群流调,肺结节检出率为16.9%,而研究表明国际上的肺结节检出率大概在18%-19%,国内和国际差别不大。但是我们可以明显地看到检出率主要集中在30岁-70岁年龄段之间。因此,临床上肺结节的检出率如果为16%-17%,那它就是临床上相当常见的问题。那么针对肺结节,临床医生如何处理及如何做好诊断,是非常具有挑战性的工作。

肺结节病因

实性结节和磨玻璃结节的病因不同,但总体来说病因有结核、炎症等。最重要的是临床医生如何把恶性结节和非恶性结节区别开,这是首先要解决的问题。
临床困境
根据NLST试验研究数据发现,尽管肺结节检出率高,但是现在通过大型筛查发现,仅有一小部分(约4%)是恶性病变。那么问题来了,临床发现的大量肺结节患者,如何知道哪些病人是在4%以内?这是临床医生难以判断之处。

如上图所示,一般来说这么小的病灶我们可能忽略,但这个病人做了手术,不仅是恶性肿瘤,而且是微浸润腺癌。实际上我们在临床上要把这么多结节甄别出来,是十分具有挑战性的。病人一旦患有肺结节,也面临着很多问题,比如焦虑、心理压力等。所以我们既不能过度诊断,但也不能延误诊断。
二、肺结节与常见疾病影像特征
接下来就要明确哪些疾病能够出现肺结节,结节具有哪些特征?
肺腺癌
首先是肺癌。现在肺腺癌的发病率在肺癌中占比较高,它可以表现为GGO,可以是一个癌前病变,我们叫不典型腺瘤癌增生或者是原位癌,这个时候如果是原位癌,手术效果是相当理想的。一旦它出现实性成分,有可能就变成一个微浸润癌。随着实性成分不断增加,恶性成分就越来越多,当它完全变成实性的,就发展为一个浸润癌。这样的病人大家基本上都能诊断清楚,我们应该争取在恶性程度增高这个阶段之前把病人诊断清楚,这样5年乃至10年的生存率都非常高。因此,肺腺癌结节的特征还是非常不一样的。

不典型腺瘤样增生(AAH)
在临床上经常手术切除后发现是AAH,关于AAH的病人是否需要手术还存在很大的争议,有的认为不需要手术,观察就可以。那么我们在术前怎么评判是否为AAH?其实具有一定特征。一般来说,多位于肺外周,多<5mm,圆形或类圆形,边界清楚,多发更常见,绝大部分是均匀的纯磨玻璃影,里边没有实性成分。组织学检查AAH呈轻度到中度非典型立方柱状上皮细胞沿肺泡和呼吸性细支气管上皮增殖,无浸润,这样在临床上诊断AAH应该没有问题。但是,如下图所示,这个病人是多灶性病变,现在多灶性结节有所增多,会给临床的处理上带来一定压力。

原位癌(AIS)
接下来再发展就是原位癌。一般来说,多位于肺外周,多为单发,病灶比AAH更大,形状可为圆形、类圆形或不规则,边界清楚,可为纯磨玻璃影。现在计算机可以测量CT值,我们应该定量分析,观察CT值,不透明程度较AAH高。组织学呈纯粹的贴壁生长,无基质、血管或胸膜浸润。一旦遇到密度稍微高一点的磨玻璃结节,要谨慎,它很可能已经是原位癌,此时手术仍然是非常理想的效果。

微浸润性腺癌(MIA)
进一步发展里面出现实性成分,或者结节的大小逐渐增大。微浸润性腺癌多位于肺外周,多为单发,一般<2cm,一般到了2cm就更严重了。最主要的是影像学多表现为边界清楚的部分实性结节,GGO比例>50%,实性成分多≤5mm。组织学上肿瘤细胞贴壁生长为主,多为非粘液型。此时要考虑微浸润的问题,这个时候手术效果还是非常好的。

浸润性腺癌(IA)
病灶较前几种类型更大,多为实性或以实性成分为主(>5mm,GGO比例<50%)的结节,形状多为不规则,边界较清楚,开始出现一些明显的肿瘤征象,可有分叶、毛刺、棘突、空泡征、支气管充气征、血管集束征、胸膜牵拉征等。临床医生判断这些征象没有什么问题,但是这个时候对于呼吸医生来说,应该在这之前给病人一个比较合理的判断。

肺鳞癌
鳞癌也可以出现一个结节,以前我们总觉得抽烟的病人患鳞癌以中心型多见,但是别忘了它也可以表现为周围型,而且容易出现小的空洞,这一点要特别注意。肺鳞癌多为单个实性结节或肿块,可见分叶、毛刺、空洞、支气管充气征、血管集束征、胸膜牵拉征。另外,如果肺上叶出现这样的结节,医生要进行一系列的鉴别,比如结核、真菌、感染、血管炎等,但是更要注意还有一个肿瘤的问题需要排除。

小细胞肺癌
小细胞肺癌以中央型多见,但是也有少数为周围型病灶。多为单个实性结节或肿块,可见分叶、毛刺、血管集束征、胸膜牵拉征。实际上我们很难从影像学上判断出小细胞肺癌的病理类型,往往是活检或者手术以后才能证实。如下图示,这属于I期的小细胞肺癌,进行手术的效果非常好。所以对于周围型小细胞肺癌,如果在结节很小的时候判断出来就做了手术,疗效非常好。我们知道小细胞肺癌是肺癌中治疗效果最差的,恶性程度是最高的。如果早期手术,仍然能够起到很好的效果。
转移癌
肺部转移性恶性结节常为多发,但也可见到单个转移性实性结节病灶,要注意这一点。

类癌
我们在临床上经常能够见到类癌,多发生于大气道,所以介入治疗相当一部分是要处理类癌。约20%发生于肺外周,多表现为单发的实性结节。实际上从影像学上诊断类癌很困难,有人提到类癌瘤内钙化发生率<10%,但是从影像学判断是很有难度的。

错构瘤
错构瘤多位于肺周边和低垂部分的单发灶,有比较明显的特征,边界清,可有浅分叶,无毛刺,约50%可显示脂肪成分,25%有钙化,呈典型的爆米花样或斑点状。以前我们不太注意有脂肪成分,现在文献中提到一个结节里面如果含有脂肪成分,那就特别有意义,提示它可能是个良性病变。当然,我们要从多维度来看,现在讲究CT影像不是讲一个指标,是讲一组指标,且还要定量分析,所以我们要从经验性逐步走到定量分析。

动静脉畸形
还有一点要提醒大家的就是血管畸形。多表现为圆形或轻度分叶的致密影,多位于肺门附近的肺内带,增强扫描时病变区强化明显供应动脉及引流静脉更加清晰。所以现在有的病人发现了结节,还是有必要做增强CT,为什么?如果你觉得这个结节没做过增强CT,靠活检、胸腔穿刺或者导航,如果病人是血管畸形,那必然会大出血,要面临很严重的并发症。所以对于结节病人,如果你采用介入性的或者是侵入性的诊断方法时,需谨慎一些,为了防止活检大出血,最好做个增强CT以观察。

结核
结核是经常要做鉴别诊断的。根据病人感染的时机、病人的免疫状态不同,结核病会有不同的反应,因此肺里面可以有各种各样的表现,临床很难把握。所以在鉴别诊断结节的时候,一定不要忘记还要与结核相鉴别。

结节型结节病
结节病在呼吸科不是很少见,也不是很常见,但是在做结节诊断时,一定要考虑结节病的可能。对于结节病来说,除了结节以外,我们还要关注肺门淋巴结、纵膈淋巴结,这对诊断具有一定帮助。文献上有提到,星云征对结节病具有一定的诊断价值。

炎症
炎症不一定都是感染性引起的,因为肺部与大气相通,难免有一点雾霾吸入肺里会产生反应。这种炎性的阴影,很难和刚才提到的肺腺癌进行鉴别诊断。所以我们发现这种磨玻璃结节和炎症结节,临床上建议一定要有一段观察的时间,以防和炎性疾病混淆。所以有的文献上报道要观察三个月,三个月后如果结节消失了,问题就迎刃可解。肺结节单纯从影像学上来说,有时很难进行鉴别,因此用时间来观察动态变化十分重要。

良性肉芽肿
良性肉芽肿呈圆形,密度可能比腺癌稍微高一点,单发或多发的实性或亚实性小结节影,多位于胸膜下。尤其是表现成亚实性的时候,和腺癌的鉴别十分困难,所以良性肉芽肿也不好判断。

肺曲霉菌病
肺曲霉菌病可以表现为单发或多发的结节或肿块,边缘模糊,有的聚集成簇。感染早期可见胸膜下密度增高的结节影,病灶周围可出现晕征。发病10-15d后,肺实变区液化、坏死,可见空腔阴影或空气新月征。所以肺结节的鉴别诊断还要考虑是否存在曲霉菌感染。

肺隐球菌病
肺隐球菌病往往在手术或者活检后才能明确诊断,肺泡腔部分被隐球菌和炎症细胞占据,病情逐渐发展病灶转为实性结节,无GGO成分。可以在相对健康的人群中发生,包括体质很好,没有基础疾病的人群。因为结节做手术,最后病理是隐球菌病的不在少数。因此肺隐球菌病有相当一部分是怀疑肺癌,在手术以后才明确诊断。所以在做鉴别诊断时,要注意还有隐球菌,而隐球菌抗原检查可以提供鉴别依据。

局灶性机化性肺炎
机化性肺炎有一个特点,它会有动态变化,大小和形态都有很大的变异,形态不规则呈多角形,贴近胸膜面(可有局限性胸腔积液)或沿支气管血管束分布,有粗长毛刺、尖角、向心性弓形凹陷、支气管扩张,部分病灶中心可出现低密度区(增强时呈周围强化),部分病灶边缘可见肺泡隔增厚而使边缘清晰,纵膈、肺门淋巴结增大较少见。

多灶性COP
多灶性机化性肺炎也可以表现为胸膜下或支气管周围的磨玻璃密度片影伴实变,支气管或细支气管周围边界不清的磨玻璃密度小结节,大的结节和肿块,反Halo征。因此,大家在做肺结节鉴别诊断的时候一定要考虑到该疾病。

BOOP
双肺多发的磨玻璃影或斑片实变影,沿支气管血管束分布或位于胸膜下,在一个或多个结节内可见到支气管充气征,有时可见反晕征。临床上要是碰到多发性肺结节超过五个的问题倒不大,要是只有两、三个还是需要警惕的。

过敏性肺炎
过敏性肺炎在两肺散在分布,边缘模糊的小叶中心性小结节或网状结节影,形状不规则,斑片状磨玻璃密度影,区域性肺灌注减低,但是具有易变性。过敏性肺炎和AAH在影像学上很难区分。

嗜酸性粒细胞性肺病
ELD中单纯性嗜酸性粒细胞增多症(SPE)、特发性嗜酸性粒细胞增多综合征(IHS)可呈GGO结节表现,不具备特征性。SPE的GGO结节多为周边分布,可单发或多发,边缘模糊,具有游走性,1个月内可消失。因此我们在临床上不仅要观察影像,还要观察血常规、IgE等有无变化。所以我们的思路在做肺结节诊断的时,一定要开阔一点,不能只想到肺癌、结核,还有很多的疾病需要考虑。

常见疾病影像特征小结
常见的这些疾病表现为肺结节,实际上在临床很难掌握。不同的病因有相似的影像表现,仅少数疾病有较特异的影像特征,大部分疾病很难基于影像确诊,动态观察还是非常重要的。除此之外,须结合临床、实验室检查和其他诊断技术进行综合分析,仔细鉴别。
三、肺结节与常见影像特征
常见影像特征

我们怎么判断一个结节的特征?总的来说,可以从这几个方面入手:结节的大小、部位、密度、形状、边缘、内部特征以及复杂特征。对于临床医生而言,观察一个胸片,要综合很多的指标来衡量这个结节,不仅是看大小、密度,需要给予比较全面的分析。
大小与位置
有研究表明右上肺出现结节,肿瘤的概率比其他部位要高;外周出现结节的肿瘤的概率比较高。因此,右上肺是恶性结节的好发部位,恶性结节多位于外周,外周型腺癌接近胸膜的占82.2%,外周型鳞癌接近胸膜的占62.9%。但有,我们国家是结核的高发地区,结核发生在双上肺的比较多。而西方国家的结核很少,右上肺出现一个结节当然会考虑肿瘤。因此,不同地区、不同人群结节的病因也是有差异的,大家要区别对待。

结节的大小是绝对有价值的。一般来说,1cm以下良性的可能性占比较多,超过1cm,尤其超过2cm的结节,要格外小心肿瘤。因为很多研究证明直径大小是判断良恶性的独立危险因素。

密度——实性成分
我们不仅要注意整个结节的密度,现在大小乘以密度叫mass,这样来评价结节良性、恶性的可能性,比较精准。实性成分是最可怕的,有实性成分的结节就是所谓的混合性结节。

内部特征——钙化
30年前的影像学理论曾提到,结节里如果有钙化就强烈提示为良性病变。但是现在的研究结论则表明,良性病变钙化多为弥漫实性、中央型、边缘型、爆米花型、板层状钙化;恶性病变主要为散在、偏心点状钙化(数量少);位于尖段新发的、缓慢生长的钙化结节须随访。现在出现钙化不足以为一个独立的证据,所以要谨慎对待钙化。

弥漫性钙化

这个病变整个都钙化了,多见于良性病变。
中央型钙化

出现在较为中心位置的钙化,多见于良性病变,在SPN中的发生率低。
「爆米花样」钙化

这两种爆米花样的钙化和层状的钙化,是错构瘤。
层状钙化

一层一层的钙化多见于良性病变。
脂质密度

我们以前不太重视脂肪的密度,CT值在-40至-120间表明为脂质密度,60%的错构瘤中可见。所以大家不要只关注密度,也要关注一下脂质密度,密度高的在片子上容易显示出来,容易引起注意。密度低的话,如果不去测不去看,容易忽略,低密度同样有重要意义。
形态


这个病变很不规则,这种多形性病变多为良性,如纤维化,局限性肺不张。
肺裂结节

现在的研究总会提到肺裂结节(PFN)。叶间裂的里边出现一个结节,三角形、多边形、卵圆形或扁豆形,位于胸膜15mm以内范围,典型和不典型PFN主要为良性,主要考虑为肺内淋巴结。
边缘特征
光滑或粗糙

边缘光滑多为良性病变,但仍有1/4-1/3的边缘光滑结节为恶性病变,因此不能作为排除恶性的标准(左图)。边缘粗糙表明肿瘤沿肺泡壁侵袭,多见于肺腺癌(右图)。
毛刺征

短毛刺(左)长毛刺(右)
毛刺又分长毛刺和短毛刺,短毛刺为肿瘤细胞向邻近肺实浸润时,支气管血管鞘或局部淋巴管阻挡,或肿瘤的促结缔组织生成反应的纤维带,其预测恶性的阳性预测值88%-94%。长毛刺是炎性的表现,良性病变边缘亦可见毛刺,多较长、柔软,常由增生的纤维结缔组织所形成,如炎性假瘤和结核球的毛刺为纤维包膜外增厚的小叶间隔。但是长度多少叫做长毛刺,多短叫短毛刺,没有明确定论,但是总体来说毛刺还是有一定规律的。
分叶征

除了实行成分以外,磨玻璃结节出现分叶也有意义。肿瘤在肺小叶内扩散,瘤体各部生长速度的不同,或生长的同时遇到血管或支气管的阻碍形成分叶。有人认为分叶征对恶性结节的阳性预测值是80%,但25%的良性病变如错构瘤也可有分叶征。
晕征

晕征多见于良性病变,如肺曲霉菌病、卡波西肉瘤、肉芽肿病、血管炎(韦格纳)和转移性肉瘤。如果结节周围出现出血,可能出现晕征。但肺腺癌因附壁式生长也可以出现晕征。所以鉴别起来并不是很容易,要从多个指标观察。
内部特征:支气管充气征

支气管充气征可能表现为各种形式,支气管被肿瘤组织包挠,未完全塌陷,或瘤组织在细支气管表面呈附壁式生长而不充盈管腔,也可为扩张的细支气管。
这是几种特殊类型的支气管充气征:

Ⅰ型和Ⅱ型做导航的话结果都非常好。对于各种各样的支气管征象来说,现在有分型软件,可以进行三维重建,作为一个非常重要的指标。因此,我们观察结节,不能光从一个层面看,要从多个层面去观察气管、血管等多个的征象的变化。
内部特征:空泡征

空泡征由未被肿瘤组织占据的肺组织,以及小气道阻塞后残存的肺泡腔隙破坏、扩大、融合所致。左图的空泡基本没问题,右图的空泡需要多加注意。
内部特征:燕麦圈征(开放支气管征)

还有非常容易被大家忽略的一个特点(如上图所示),文献上把这个病灶称为燕麦圈征,这不是个好征象。由开放气道周围的肿瘤细胞或非肿瘤细胞增生所致,多见于肺腺癌和肺朗格汉斯细胞组织细胞增多症。尤其是女性病人出现这种征象的概率比较高,出现之后一定要手术。
内部特征:空洞

空洞可在坏死性恶性结节如鳞状细胞癌中看到,也可见于良性结节,如脓肿、感染性肉芽肿、血管炎、淋巴细胞性间质性肺炎、早期的朗格汉斯细胞组织细胞增生症、肺梗死。
内部特征:囊性空腔

这个征象大家也要特别注意,当周围空腔壁增厚、空腔壁上出现结节时须高度关注,不要认为这样的都是肺大泡而把它漏诊。
血管集束征

血管集束征是肿瘤组织向血管支气管鞘或小叶间隔浸润生长,瘤体内纤维组织增生或瘢痕形成牵拉临近血管向瘤体集中所致。
胸膜牵拉征

胸膜牵拉征是由于小叶间隔增厚、外围血管受阻引起的纤维化以及肿瘤细胞侵犯淋巴道和胸膜所致。
卫星灶

观察结节周围是否存在卫星灶,对临床医生的判断也非常重要。卫星灶多见于肉芽肿性炎,如结核。
GGO

我们再谈一下GGO的问题。刚才谈到了GGO是一个动态的变化,可以先是磨玻璃样的结节,逐渐有实性成分,最后实变。GGO如果出现实性成分的话,一定要提高警惕。
GGO重要特征

刚才提到,GGO也可以有分叶征,对肿瘤的诊断特别有意义,也可以出现空泡征、支气管充气征、血管集束征、牵拉征,同样具有意义。
GGO实性成分

反复强调了GGO的实性成分标志着腺癌的不断发展。
常见影像特征与临床意义
肺结节的大小、实性成分有较好的预测价值;钙化和脂质密度、长毛刺、有卫星灶多见于良性结节;分叶征、短毛刺、空泡征、支气管充气征、血管集束征、胸膜牵拉征多见于恶性结节。这些征象要综合分析,不能仅凭一个征象做结论。
微小肺结节(肺癌)的诊断价值?

我们刚才看到的征象都是比较典型的。如上图所示的小结节,什么征象都没有,判断为良性也很困难。刚才提到的那么多结节的特征,在微小结节中少见,价值有限。因此,如何提高微小结节的诊断水平是关键,因为在早期手术效果相当好。
微小结节影像特征

国内、国外都有学者做微小结节相关的研究,以上是张国桢教授的书中所描述的征象。肿瘤的生长需要血管,没有供血的话无法生长。肿瘤的供血很丰富,里面血管很紊乱。这个时候如果我们用现代增强CT扫描,用薄层CT、三维重建,可以看到滋养血管进入肿瘤,我们叫做肿瘤微血管移动征。如果「肿瘤血管」增生形成杂乱新生的毛细血管网,我们叫做联通征。这有助于肺癌的早期诊断。
微小结节的影像特征——周围血管特征

现在有数字肺软件等多种技术,可以对血管进行定量的分析,显示出立体结构,观察结节有多少个血管、进去的角度怎么样、指向如何等等,这些都非常有意义。
四、肺结节的各种诊断方法与评价
除了影像学诊断以外,还有哪些检查对肺结节的判断具有价值?
临床特征

我们是临床医生,不是影像科医生,因此要特别关注患者因素、环境因素、临床症状。这些都对良恶性鉴别具有一定价值,更多体现在对有症状的良性结节的判断上,对处置策略的制定具有重要价值,我们对有恶性风险因素的患者处置更为积极。
Biomarkers
传统实验室Biomarkers

临床上检查血常规、感染相关指标、风湿免疫相关抗体,肿瘤标记物有很大的临床意义。但是现有的肿瘤标记物,比如癌胚抗原(CEA)的敏感性有限,后面会介绍现在有新的生物标志物出现,对肺结节的诊断提供帮助。
现代基于液体活检和分子生物学方法的Biomarkers

现在血、痰、CTC叫做液体活检,还有呼出气、自身抗体的检查。目前尚无特异性生物学标志物应用于恶性结节的临床诊断,仅自身抗体联合LDCT可用于肺癌筛查。现在自身抗体检查已经上市,各个医院都有应用七种抗体的方法,还是非常有意义的,值得大家来应用。
CT
推荐肺结节患者行胸部CT检查(结节处行病灶薄层扫描),薄层(≤1mm层厚)的胸部CT可更好地评价肺结节的形态特征,分析肿瘤体积可科学地监测肿瘤生长,建议设定低剂量CT检查参数和扫描的范围。
CT影像后处理

为什么要看电子版CT?除了我们从一个层面看,还可以做多平面重建(MPR)、最大密度投影(MIP)、容积再现(VR),这一系列的处理方法完全改变你对这个结节的看法,有时候观察平扫觉得这个结节有问题,但是平面重建后显示这个结节没有问题。所以CT影像后处理相当重要,呼吸科医生也经常看胸片,有些工具要会使用。
MRI

我们总觉得磁共振对肺结节的意义不大,但是现在认为增强MRI对血管的判断具有意义,这值得大家的关注。
PET-CT

PET-CT对肺结节有一定作用,不同大小、不同类型的肺结节,有不同的诊断价值。但对于纯GGO,PET-CT的诊断价值有限;而对于部分实性GGO,PET-CT有一定价值。指南仅推荐>8mm实性结节或实性成分>8mm且具有高危因素可行PET检查。
诊断模型

大家一定要重视诊断模型,因为它会综合诸多的临床数据、各项检查结果、影像数据,以后会发展到与Biomarker的数据相结合并提供一个模型,利用模型来分析结节的风险,最终做出不同的处理。

目前国际上有我觉得比较好的模型是梅奥模型和北大模型,使用率也比较高。对于做相关研究的医生们使用模型较多,但临床医生重视度有待提高,模型对于肺结节的诊断还是非常有意义的。
非手术活检

临床上,肺结节诊断得有病理才能确诊,不做手术就能得出病理的手段叫做非手术活检。

非手术活检的适应症
CT引导下经皮肺穿刺——同轴穿刺活检

同轴穿刺活检利用套管针与活检枪分离,可更换角度多次活检,一次穿刺多次活检,进一步克服肿瘤病灶的不均质性,提高阳性率。套管针贴在病灶表面,利用活检枪激发,可减少甚至避免针道转移。其相对常见并发症包括出血、气胸,而针道转移罕有报道,目前无客观证据显示活检有增加转移或促进病情恶化的风险。其诊断敏感性97%,特异性100%,准确率97%,敏感性和准确率随SPN直径增大而升高,且气胸发生率12.3%,咯血发生率20%,均为轻度。
导航支气管镜活检

最近大家很感兴趣的就是导航技术,有超声导航、电磁导航、4D电磁导航、LungPro导航等。做外周病变小结节的活检,以前只有40%会出结果,现在利用导航技术基本上70%-80%都能够有活检病理的结果。
电磁导航Meta分析

这是2020年《CHEST》发布的电磁导航Meta分析,敏感性能够达到77%,气胸发生率是2%,较传统方法相比有明显进步。
非手术活检的局限性

但是非手术活检获取的标本都是小标本,所以取标本有限。如果病理报告基于针尖大小的组织样本,那就存在许多不确定性。上图所示,是我们的一个病例,4月21日,外院CT引导下经皮肺穿刺,我院病理会诊为慢性炎症;5月16日入院,我建议再做一次活检,于是5月19日经皮肺穿刺,病理提示还是慢性炎症;两次病理提示均为慢性炎症,但是完全用慢性炎症解释这个肺结节还有些疑问,我建议再做一次经皮肺穿刺,6月7日第三次活检的病理结果提示为中分化腺癌,而且基因检测提示ALK阳性,是黄金突变,靶向治疗效果很好。因此,我们取小标本的时候,要慎重解释阴性结果。
五、临床诊断程序与处理决策
病人是继续观察,还是手术治疗?医生做出的临床诊断和处理决策十分重要。
肺结节的临床决策

国际上基本上是根据病人的危险因素、临床因素、Biomarker、影像特征,做恶性概率的模型评估,如果是低风险则继续观察,中风险有可能要进行非手术活检,高风险就直接进行外科手术。问题就是出现在中风险,放过也不合适,做手术有点唐突,所以这部分的病人最为困难。
肺结节临床处理的基本流程

实性结节临床管理流程(CTS肺癌学组)

六、有关问题与思考
上述讲到的理论知识,实际上在临床操作起来存在很多困难。因此,我们要阐述有关诊断治疗的问题。
1动态变化与随访
什么样的病人适合随访?

低风险人群适合随访观察。

要观察大小、实性成分和形态的变化。大小的变化很有讲究,现在国际上比较推荐使用容积法(3D),需要专用软件来测量,一定要减少误差。
GGO自然变化与随访结果

基本上是这几种随访结果:第一种,结节没有变化;第二种,实性成分增多;第三种,结节消失。后两种都好处理,关键是没有变化的GGO,下一步该怎么办呢?国际上建议,GGO观察三个月,如果持续存在,结节实性成分>5mm可以手术;大小长到了1.5cm,要密切观察或者直接手术;如果稳定至少要观察三年。如果是混合性实性结节,实性成分>5mm可以手术;如果大小>15mm可以手术,针对不同的情况,都有不同的规定。
CT随访
1)病灶大小无变化、实性成分增多

这个结节大小没有太大变化,实性成分增多,这不是一个好征象,可以考虑手术。
2)病灶缩小、出现实性成分

容易被大家忽略的是结节的大小变小,但实性成分增多,值得大家重视。不要认为结节变小了就一定是良性。
到底随访多长时间?


文献和指南都有提到随访时间,但实际上磨玻璃结节从开始到后面可以好多年不变化。我们要随访多少年,没有统一定论,要根据病人的个体情况来决定。因此随访时间要个体化。

观察时间与临床可操作性?


实际在临床上操作起来存在困难,有的病人不在乎有结节,但有的病人就会很紧张,做了很多胸部CT,也无法下结论,长期随访观察下去患者就会很焦虑。
随访放射暴露问题

经常拍胸部CT,有关放射暴露的问题要引起大家注意。建议与放射科联合,设置专用的结节评估LDCT方案。
2、诊断性治疗?
解决磨玻璃结节能否做一些治疗?
第一,我们考虑能否使用抗生素,很坦率地说,缺乏高级别证据,这次指南上没有推荐经验性抗感染治疗。实际临床上医生还会使用,但不是所有病人都要用抗生素,判断有炎症可能性的病人可以考虑使用,使用哪种抗生素、用多长时间没有规定。
第二,有些病人会询问医生,这不是考虑肺癌吗?现在有靶向药,可不可以吃点试试?千万不能这样做,没有病理诊断不能用靶向药。
第三,还有人说能不能使用激素治疗,如果嗜酸性细胞高或者IgE特别高,偏重于机化性肺炎或者过敏性肺炎,可以谨慎考虑,但不作为推荐,一定要弄清楚诊断。原则上不赞成使用激素进行肿瘤的治疗。
3、非手术治疗?
不论磨玻璃结节是良性、恶性,现在有微创的办法可以治疗吗?比如放射治疗、射频消融、放射性粒子植入,不是说绝对的不能,但是要有前提条件,首先是高度可疑恶性的早期病灶,而且在病人高龄、基础器官功能储备不足、拒绝外科手术等情况下,才能谨慎地考虑。因为没有确诊就使用这些治疗会影响病人的后期观察。如果你考虑为肿瘤,磨玻璃结节也好,小结节也好,I期手术是可治愈的,而这种微创手术能否达到外科手术效果,我们需要大量研究来证实。所以在未证实之前,大家要谨慎选择。
4
最后决策与病人参与
最后决策病人到底是手术还是观察,除了医疗问题以外,还有社会问题、经济问题以及病人的心理问题。结节的处理诊断不只是医生的问题,医生要与病人一起考虑最终是否需要手术治疗,强调病人要参与决策过程。
七、多发性GGO问题

多发性GGO可以是一个结节为主、有多个结节,我们叫主病灶和次病灶。它可能同时发生,也可能在随访过程中逐步发生。各种情况都有,它的意义是不一样的。关于多发性GGN的诊断,病因更多,病情更复杂,所以我们处理起来更困难一些。
基于mGGNs中主病灶的临床决策

我现在特别赞成文献上提出的按主病灶为准来处理,也叫突出病灶,这种病人手术效果也很好。所谓的「打地鼠原则」,地鼠往上一冒头,就用锤子把地鼠打下去。对于多病灶来说也是一样,哪个病灶出了问题就处理哪个病灶,就是「打地鼠原则」。这是我认为目前临床上比较好的多发性GGN处理的一种方式,大家可以借鉴。
八、最新指南简要介绍
肺结节相关的主要指南

主要指南如上图所示,总体处置比较一致,ACCP和CTS关于8-30mm实性结节的处置更为积极;强调处理的规范性,同时兼顾个体化和本地化的处理策略。
九、进展和展望
主要涵盖以下四个方面:1)定量CT和新的影像特征,2)影像组学与影像基因组学,3)Biomarkers,4)大数据整合分析与AI决策,机器人与内镜微创诊疗新技术。

我们不仅要考虑结节的容积,还要考虑它的平均密度,结节质量(Mass)=容积×平均密度。现在根据Mass来判断恶性的可能性有多大,所以远远超过我们临床医生看一个直径,看一个长乘宽。另外,我们看实性成分比值、GGO比值,这是计算机给出的数据,所谓的定量。
影像组学与影像基因组学

组学技术(OMICS)——Biomarkers

组学技术——呼出气组学(Breathomics)

在组学技术中,我要特别和大家提一下呼出气组学。呼出气在我们呼吸领域的哮喘、慢阻肺患者中使用较多,其实用于肺癌的筛查也很重要。上图为我的一位学生做的工作,研究结果表明呼出气检查对于肺癌的诊断很有帮助。
大数据与人工智能用于肺结节辅助诊断
识别结节,进行数字化定量分析,把临床大数据、影像组学、生物组学大数据和病理大数据进行大数据综合分析,最后利用人工智能来决策结节的处理办法,给出一个处理决策方案,这是未来的发展方向。
内镜微创诊断新技术

机器人会以导航支气管镜作为一个平台,在未来肺结节的诊断和治疗中会发挥很大的作用。
感谢
最后,我要特别感谢我的团队,他们在肺结节的影像诊断和介入治疗方面做了大量的工作。特别感谢杨震教授、赵微教授、梁志欣教授在幻灯片的制作中提供了很多帮助。还望大家批评指正,谢谢。
专家介绍

陈良安
解放军总医院呼吸与危重症医学部学术主任,全军呼吸病研究所所长,主任医师、教授,博士生导师。中华医学会呼吸病学分会副主任委员,中华医学会内科分会候任主任委员,中国医师协会呼吸分会副会长,全军呼吸病专业委员会主任委员,北京医学会呼吸病分会候任主任委员。

梁志欣
解放军总医院呼吸与危重症医学科副主任,主任医师、副教授、硕士研究生导师,中华医学会呼吸病学分会青年委员,中国医药教育协会介入微创呼吸分会副主任委员,中国医师协会呼吸医师分会慢病预防工作组副组长,军队呼吸内科专业委员会青委会副主任委员。
* 感谢杭州凯保罗生物科技有限公司大力支持
本文完
排版:Jerry
本文由《呼吸界》编辑 大奔 整理,感谢梁志欣老师的审阅修改!